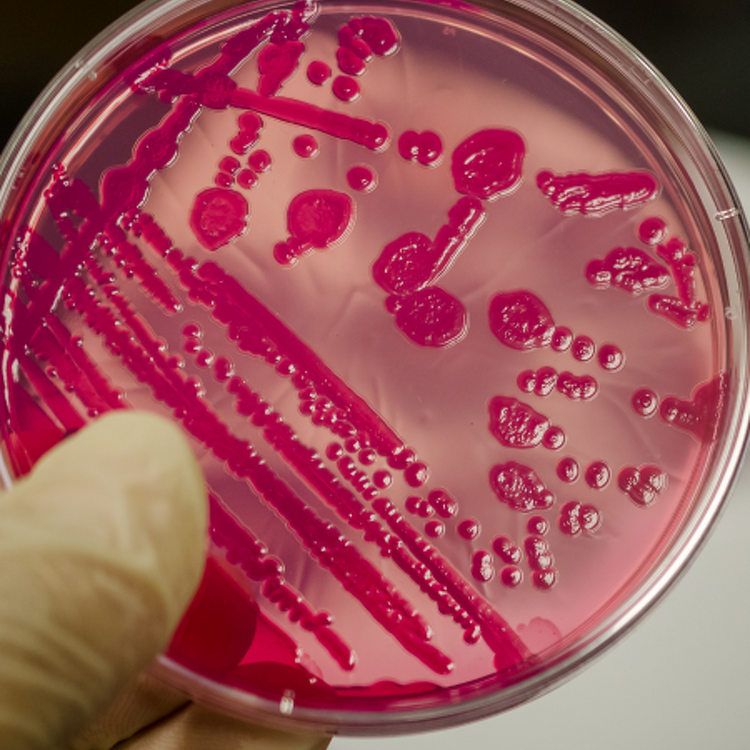

Common Diseases
What you need to look out for
Information from our farm veterinary team on diseases commonly seen on New Zealand farms.
Bovine Viral Diarrhoea (BVD)
Bovine Viral Diarrhoea (BVD) is a globally prevalent cattle disease that impacts reproduction, lowers beef and milk yields, and increases susceptibility to other illnesses—causing major economic losses across the livestock industry.

Leptospirosis
Leptospirosis (Lepto) is a serious bacterial disease spread through the urine of infected animals. It can affect cattle, sheep, goats, pigs, dogs, horses, rats – and humans.
Vaccination is the best protection. The Lepto‑4‑way vaccine guards against four key strains.
Lepto 4-Way®
Lepto 4-Way® is an inactivated leptospirosis vaccine developed in response to the emergence of the Tarassovi-like serovar, ‘Pacifica’. As well as Tarassovi, the vaccine also contains serovars Hardjo, Copenhageni and Pomona - serovars that have been identified to cause disease in livestock and humans in New Zealand.
Lepto in calves can strike suddenly, often causing high death rates at 3–4 weeks of age. Early vaccination (first dose at 3–6 months, booster 4–6 weeks later) prevents “shedder” calves and reduces risk during wet conditions.
- Vaccinate your herd before calving to protect calves early
- Keep your staff, animals, and family safe.
Salmonella
Salmonella is a highly contagious cause of diarrhoea in calves aged 2–12 weeks. Symptoms include fever, foul‑smelling watery or mucoid diarrhoea (sometimes with blood), and high death rates. Infection spreads through contaminated feed, water, or the environment, and is worsened by poor colostrum intake, wet or crowded housing, poor hygiene, or introducing stressed carrier calves.
Prevention is key
- Ensure calves receive adequate colostrum
- Vaccinate cows pre‑calving to boost antibodies
- Maintain strict hygiene in calf sheds: disinfect troughs, feeders, boots, clothing, and equipment
- Handle sick calves last, and avoid cross‑contamination between pens.
Salmonella also infects humans. Protect yourself and your family by practising good hygiene, leaving dirty boots/clothes at the shed, washing hands thoroughly, and avoiding raw milk during outbreaks.

Theileria
Theileriosis is a blood‑borne parasite disease spread by cattle ticks. It only affects cattle and is increasingly common in the northern North Island, including areas covered by Franklin Vets.
Key facts:
- Causes anaemia and can be fatal
- Highest risk: cows around calving and calves 2–3 months old
- Signs include pale vulva/eyes, lethargy, reduced milk, poor appetite, and sudden death
- Infection develops 6–8 weeks after a tick bite.
Prevention & Control
- Monitor herds using vulva colour checks and blood tests (PCV)
- Apply tick control products during risk periods (Aug–Mar, or when temps >7°C)
- Quarantine new/returning stock for 7 days and treat for ticks
- Maintain good nutrition and minimise stress during calving and peak milk production.
Johne's disease
Johne’s disease is a chronic gut illness caused by Mycobacterium avium subspecies paratuberculosis (MAP). It leads to scouring, weight loss, and eventually death.
For every cow showing signs, 15–25 others may be silently infected – making Johne’s a hidden herd problem.
Why it matters:
- Costs the NZ dairy industry $40–90 million annually in lost milk and poor calving
- Reduces milk production and reproductive performance
- Causes rapid weight loss, diarrhoea, and death
- Hidden costs: premature culling, higher vet bills, reduced slaughter value, fewer replacements, and wasted investment in young stock.
How we can help
- Diagnose Johne’s disease in your herd
- Develop tailored management and control plans to minimise losses
- Discuss testing options, including milk testing during herd checks.


Down cows & low phosphorous
Cows can go down for many reasons – from metabolic issues (milk fever, low magnesium, ketosis, acidosis) to injuries, mastitis, metritis, or calving paralysis.
Low phosphorus is a common cause, especially:
- Around calving (often with milk fever)
- In sick or off‑feed animals
- High‑yielding, older cows
- On low‑phosphorus diets (e.g. fodder beet).
Signs of low phosphorous:
- Down cow not responding to milk fever treatment “Crawler cow” unable to rise
- Loss of appetite, muscle weakness
- Red or bloody urine.
Diagnosis
- Lack of response to calcium treatment
- Confirmed by blood test.
Treatment
- Most recover with milk fever therapy (calpromag, oral drenches, anti‑inflammatories)
- If unresponsive: oral DCP (di‑cal‑phos) or veterinary injectable treatments
- If your cow is down and not responding to standard treatment, contact Franklin Vets for urgent support.
Milk fever
Milk Fever is the most common metabolic condition that usually occurs around three days either side of calving. In the early lactation stages, a high producing cow’s calcium requirements exceed her ability to mobilise calcium reserves (bones) and absorb enough calcium from the diet.
Milk fever may be seen in cows of any age but it is more common in high producing dairy cows over five years of age.
Please contact your nearest Franklin Vets if you notice any of the following problems:
- Staggering
- Lying down with head and neck kinked back
- Tremors
- Hypothermia
- Constipation.
Effective treatment with calcium can be achieved if it is administered in time. Treatment with calcium orally or under the skin may be sufficient in early cases. However, often a vet visit will be required to administer intravenous calcium, especially for cases where the animal is down. It is important to keep affected animals warm, well-fed and with fresh water available.


Grass staggers
Grass staggers (hypomagnesaemia) occur when magnesium intake is too low, especially in spring when lactating cows need more magnesium and lush pasture contains less. Adult dairy cows are most at risk, but it can also affect ewes in late pregnancy.
Warning signs
Hyper‑excitability and restlessness
Unsteady, uncoordinated movements
Over‑alert appearance.
Act fast
Treatment response can vary. Magnesium must only be given under the skin, and many cases also require calcium.
If you suspect grass staggers, contact Franklin Vets immediately.Sub-clinical ketosis
Sub‑clinical ketosis occurs when cows have high ketone levels without obvious signs. It is most common in early lactation when energy demands exceed intake, leading to fat and muscle breakdown.
Impacts:
- Increased risk of clinical ketosis and displaced abomasum
- Reduced fertility and six‑week in‑calf rates
- Lower milk production and hidden economic losses (up to $5,700 per 100 cows).
Detection
- No clear signs, but cow‑side testing can identify herd status in under an hour.
Prevention:
- Achieve condition score targets before calving
- Ensure good nutrition post‑calving
- Use Rumensin® from 3 weeks pre‑calving to reduce risk and improve milk yield.

Protect your herd & productivity
If you see signs of any of these diseases, contact your local clinic for urgent support.
